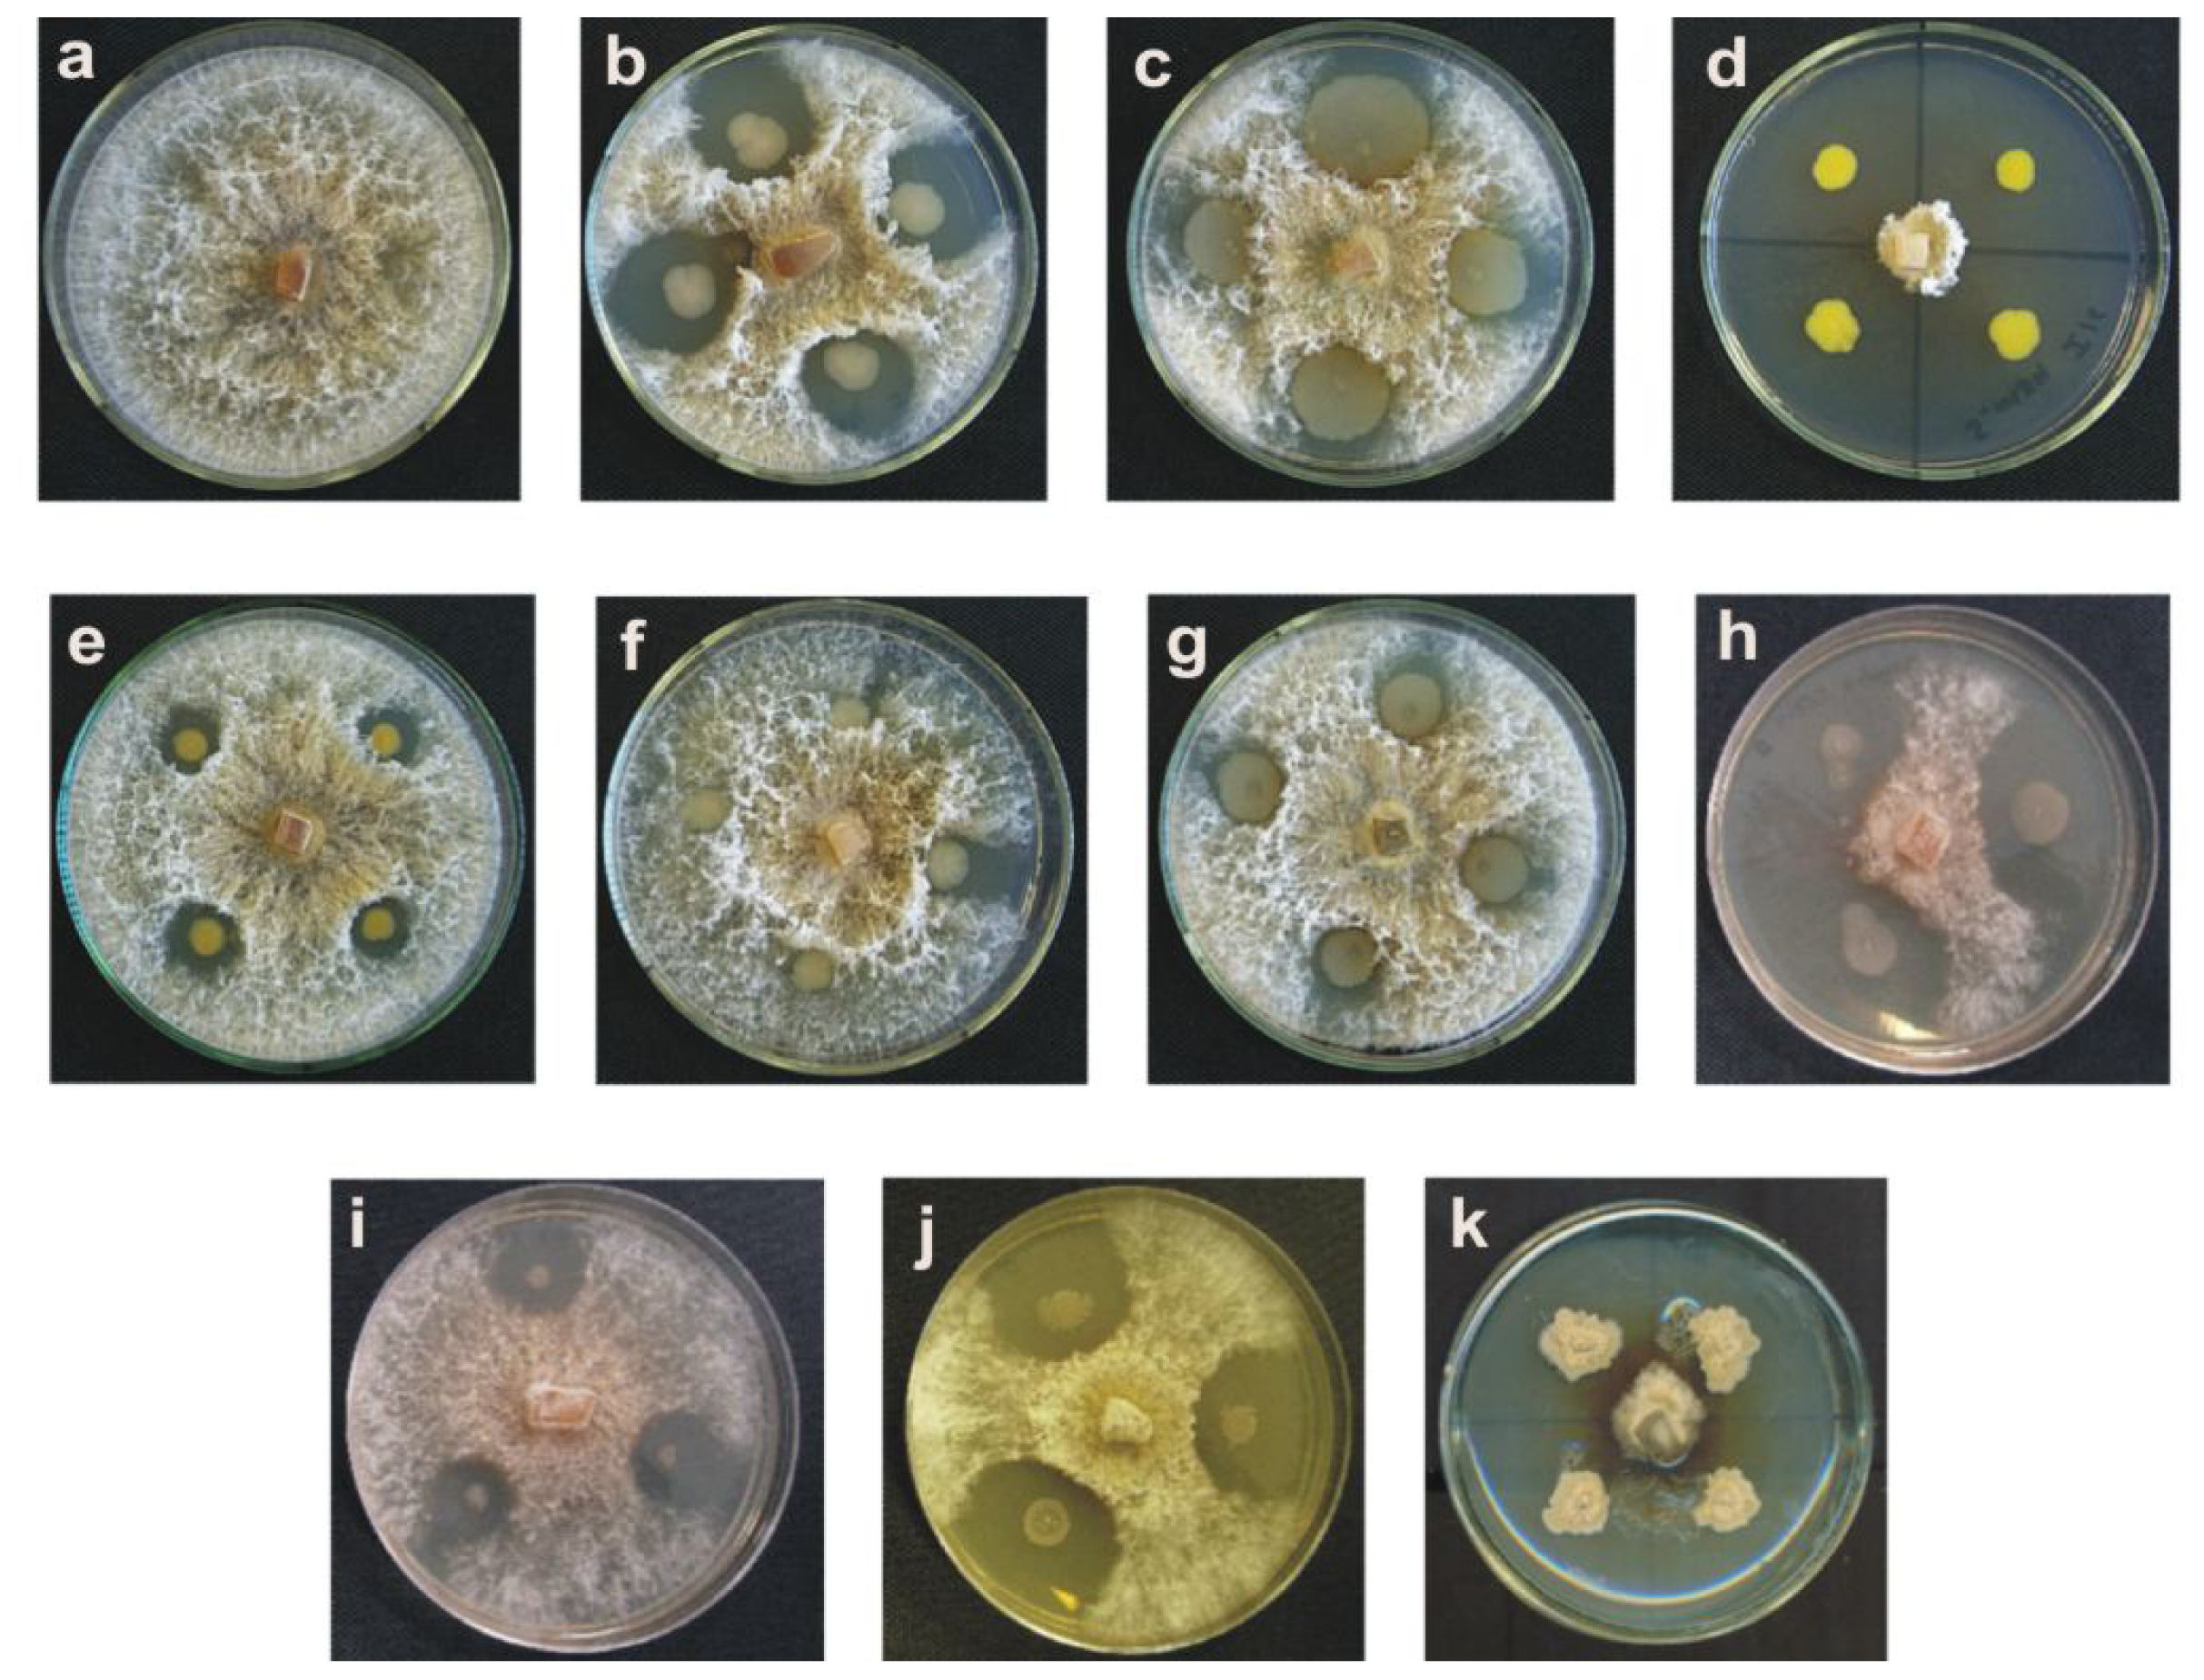
Ijms 12 05522f1 1024

Isolation of Bacteria with Antifungal Activity against the Phytopathogenic Fungi Stenocarpella maydis and Stenocarpella macrospora
Abstract
:1. Introduction
2. Results and Discussion
2.1. Results
2.2. Discussion
3. Experimental Section
3.1. Fungal strains and Growth Conditions
3.2. Isolation and Selection of Bacteria with Antifungal Activity
3.3. Identification of the Bacterial Strains with Antifungal Activity
3.4. Collection and test of Antifungal Activity of Extracellular Filtrates
3.5. Evaluation of the pH and the Temperature in the Stability of Extracellular Filtrates with Antifungal Activity and Determination of Their Cytotoxicity
3.6. Effect of the Extracellular Filtrates with the Antifungal Activity against Conidia Germination
4. Conclusions
Acknowledgments
References
- McGee, DC. Maize Diseases: A Reference Source for Seed Technologists; The American Phytopatological Society: St. Paul, MN, USA, 1988. [Google Scholar]
- Bensch, MJ; van Staden, J. Ultraestructural histopathology of infection and colonization of maize by Stenocarpella maydis (=Diplodia maydis). J Phytopathol 1992, 136, 312–318. [Google Scholar]
- Cutler, HG; Crumley, FG; Cox, RH; Cole, RJ; Dorner, JW; Latterell, FM; Rossi, AE. Diplodiol: A new toxin from Diplodia macrospora. J Agric Food Chem 1980, 28, 135–138. [Google Scholar]
- Blaney, BJ; Mannion, PE; Tuder, GD; McKenzie, RA. Examination of Diplodia maydis infected maize for toxicity to chicken and cattle. Aust Vet J 1981, 57, 196–197. [Google Scholar]
- Kellerman, TS; Rabie, CJ; van Der Westhuizen, GCA; Kriek, NPJ; Prozesky, L. Induction of diplodiosis: A neuromyco-toxicosis in domestic ruminants with cultures of indigenous and exotic isolates of Diplodia maydis. Ondersteport J Vet Res 1985, 52, 35–42. [Google Scholar]
- Rabie, CJ; Kellerman, TS; Kriek, NP; van der Weshuizen, GC; de Wet, PJ. Toxicity of Diplodia maydis in farm and laboratory animals. Food Chem Toxicol 1985, 23, 349–353. [Google Scholar]
- Rahman, MF; Rao, SK; Achar, PN. Effect of Diplodiatoxin (Sternocarpella maydis) on some enzymatic profiles in male and female rats. Ecotoxicol Environ Saf 2002, 52, 267–272. [Google Scholar]
- Vicenlli, P. Ear rot of corn caused by Stenocarpella maydis (=Diplodia maydis); Cooperative Extension Service, College of Agriculture, University of Kentucky: Stanford, KY, USA, 1997. Available online: http://www.ca.uky.edu/agc/pubs/ppa/ppa43/ppa43.pdf accessed on 1 June 2011.
- Spadaro, D; Gullino, ML. State of the art and future prospects of biological control of postharvest fruit diseases. Int J Food Microbiol 2004, 91, 185–194. [Google Scholar]
- Raaijmakers, JM; Vlami, M; de Souza, JT. Antibiotic production by bacterial biocontrol agents. Antonie Van Leeuwenhoek 2002, 81, 537–547. [Google Scholar]
- Bressan, W. Biological control of maize seed pathogenic fungi by use of actinomycetes. BioControl 2003, 48, 233–240. [Google Scholar]
- Bressan, W; Figueiredo, JEF. Biological control of Stenocarpella maydis in maize seed with antagonistic streptomyces sp. isolates. J Phytopathol 2005, 153, 623–624. [Google Scholar]
- Nogórska, K; Bikowski, M; Obuchowski, M. Multicellular behaviour and production of a wide variety of toxic substances support usage of Bacillus subtilis as a powerful biocontrol agent. Acta Biochim Pol 2007, 54, 495–508. [Google Scholar]
- Gillican, CA. Sustainable agriculture and plant diseases: An epidemiological perspective. Phil Trans R Soc B 2008, 27, 741–756. [Google Scholar]
- Manwar, AV; Khandelwal, SR; Chaudhari, BL; Meyer, JM; Chincholkar, SB. Siderophore production by a marine Pseudomonas aeruginosa and its antagonistic action against phytopathogenic fungi. Appl Biochem Biotechnol 2004, 118, 243–251. [Google Scholar]
- Nagarajkumar, M; Bhaskaran, R; Velazhahan, R. Involvement of secondary metabolites and extracellular lytic enzymes produced by Pseudomonas fluorescens in inhibition of Rhizoctonia solani, the rice sheath blight pathogen. Microbiol Res 2004, 159, 73–81. [Google Scholar]
- Compant, S; Duffy, B; Nowak, J; Clément, C; Barka, EA. Use of plant growth-promoting bacteris for biocontrol of plant disease: Principles, mechanism of action, and future prospects. Appl Environ Microbiol 2005, 71, 4951–4959. [Google Scholar]
- Kishore, GK; Pande, S; Podile, AR. Biological control of collar rot disease with broad-spectrum antifungal bacteria associated with groundnut. Can J Microbiol 2005, 51, 123–132. [Google Scholar]
- Sharifi-Tehrani, A; Shakiba, M; Okhovat, M; Zakeri, Z. Biological control of Tiarosporella phaseolina the causal agent of charcoal rot of soybean. Commun Agric Appl Biol Sci 2005, 70, 189–192. [Google Scholar]
- Afsharmanesh, H; Ahmadzadeh, M; Sharifi-Tehrani, A. Biocontrol of Rhizoctonia solani, the causal agent of bean damping-off by fluorescent pseudomonads. Commun Agric Appl Biol Sci 2006, 71, 1021–1029. [Google Scholar]
- Walker, R; Innes, CM; Allan, EJ. The potential biocontrol agent Pseudomonas antimicrobica inhibits germination of conidia and outgrowth of Botrytis cinerea. Lett Appl Microbiol 2001, 32, 346–348. [Google Scholar]
- Weller, DM. Pseudomonas biocontrol agents of soilborne pathogens: Looking back over 30 years. Phytopathology 2007, 97, 250–256. [Google Scholar]
- Mercado-Blanco, J; Bakker, PA. Interactions between plants and beneficial Pseudomonas spp.: Exploiting bacterial traits crop protection. Antonie Leeuwenhoek 2007, 92, 367–389. [Google Scholar]
- Stockwell, VO; Stack, JP. Using Pseudomonas spp. for integrated biological control. Phytopathology 2007, 97, 244–249. [Google Scholar]
- Couillerot, O; Prigent-Combaret, C; Caballero-Mellado, J; Moënne-Loccoz, Y. Pseudomonas fluorecens and closely-related fluorescent pseudomonads as biocontrol agents of soil-borne phytopathogens. Lett Appl Microbiol 2009, 48, 505–512. [Google Scholar]
- Braun-Kiewnick, A; Jacobsen, BJ; Sands, DC. Biological control of Pseudomonas syringae pv. syringae, the causal agent of basal kernel blight of barley, by antagonistic Pantoea agglomerans. Phytopathology 2000, 90, 368–375. [Google Scholar]
- Stockwell, VO; Johnson, KB; Sugar, D; Loper, JE. Antibiosis contributes to biological control of fire blight by Pantoea agglomerans strains Eh252 in orchards. Phytopathology 2002, 92, 1202–1209. [Google Scholar]
- Nunes, C; Usall, J; Teixidó, N; Fons, E; Viñas, I. Post-harvest biological control by Pantoea agglomerans (CPA-2) on golden delicious apples. J Appl Microbiol 2002, 92, 247–255. [Google Scholar]
- Nunes, C; Usall, J; Teixido, N; Torres, R; Viñas, I. Control of Penicillum expansum and Botrytis cinerea on apples and pears with the combination of Candida sake and Pantoea agglomerans. J Food Prot 2002, 65, 178–184. [Google Scholar]
- Nunes, C; Usall, J; Teixidó, N; Viñas, I. Biological control of postharvest pear diseases using a bacterium Pantoea agglomerans CPA-2. Int J Food Microbiol 2001, 70, 53–61. [Google Scholar]
- Bonaterra, A; Mari, M; Casalini, L; Montesinos, E. Biological control of Monilinia laxa and Rhizopus stolonifer in postharvest of stone fruit by Pantoea agglomerans EPS125 and putative mechanisms of antagonism. Int J Food Microbiol 2003, 84, 93–104. [Google Scholar]
- Plaza, P; Usall, J; Smilanick, JL; Lamarca, N; Viñas, I. Combining Pantoea agglomerans (CPA-2) and curing treatments to control established infections of Penicillium digitatum on lemons. J Food Prot 2004, 67, 781–786. [Google Scholar]
- Zamani, M; Sharifi Tehrani, A; Ali Abadi, AA. Evaluation of antifungal activity of carbonate and bicarbonate salts alone or in combination with biocontrol agents in control of citrus green mold. Commun Agric Appl Biol Sci 2007, 72, 773–777. [Google Scholar]
- Morales, H; Sanchis, V; Usall, J; Ramos, AJ; Marin, S. Effect of biocontrol agents Candida sake and Pantoea agglomerans on Penicillium expansum growth and patulin accumulation in apples. Int J Food Microbiol 2008, 122, 61–67. [Google Scholar]
- Munimbazi, C; Bullerman, LB. Isolation and partial characterization of antifungal metabolites of Bacillus pumilus. J Appl Microbiol 1998, 84, 959–968. [Google Scholar]
- Kim, PI; Chung, KC. Production of an antifungical protein for control of Colletotricum lagenarium by Bacillus amyloliquefaciens MET0908. FEMS Microbiol Lett 2004, 234, 177–183. [Google Scholar]
- Souto, GI; Correa, OS; Montecchia, MS; Kerber, NL; Pucheu, NL; Bachur, M; García, AF. Genetic and functional characterization of a Bacillus sp. strain excreting surfactin and antifungal metabolites partially identified as iturin-like compounds. J Appl Microbiol 2004, 97, 1247–1256. [Google Scholar]
- Arrebola, E; Jacobs, R; Korsten, L. Iturin A is the principal inhibitor in the biocontrol activity of Bacillus amyloliquefaciens PPCB004 against postharvest fungal pathogens. J Appl Microbiol 2010, 108, 386–395. [Google Scholar]
- Hucker, GJ; Conn, HJ. Further studies on the methods of Gram staining. N Y Agric Exp Stn Tech Bull 1927, 128, 1. [Google Scholar]
- Thompson, JD; Gibson, TJ; Plewniak, F; Jeanmougin, F; Higgins, DG. The Clustal X windows interface: Flexible strategies for multiple sequence alignment aided by quality analysis tools. Nucleic Acids Res 1997, 24, 4876–4882. [Google Scholar]
- Swofford, DL. PAUP*: Phylogenetic Analysis Using Parsimony (and Other Methods), 4.0b4a; Smithsonian Institute: Washington, DC, USA, 1998. Available online: http://www.sinauer.com/detail.php?id=8060 accessed on 19 August 2011.
- Solis, PN; Wright, CW; Anderson, MM; Gupta, MP; Phillipson, D. A microwell cytotoxicity using Artemia salina (Brine shrimp). Planta Med 1992, 59, 250–252. [Google Scholar]
- Stein, T. Bacillus subtilis antibiotics: Structures, syntheses and specific functions. Mol Microbiol 2005, 56, 845–857. [Google Scholar]

1,
7,
15, and ■ 30 days in the presence of 0.1 M citrate buffer, pH 3.6 (a), 0.1 M phosphate buffer, pH 7 (b) and 0.1 M Tris-HCl buffer, pH 10 (c), and assayed against S. maydis and S. macrospora in PDA.
1,
7,
15, and ■ 30 days in the presence of 0.1 M citrate buffer, pH 3.6 (a), 0.1 M phosphate buffer, pH 7 (b) and 0.1 M Tris-HCl buffer, pH 10 (c), and assayed against S. maydis and S. macrospora in PDA.
1,
7,
15 and ■ 30 days at −20 °C (a); 4 °C (b); 20 °C (c); 37 °C (d); and 50 °C (e) and assayed on S. maydis and S. macrospora in PDA.
1,
7,
15 and ■ 30 days at −20 °C (a); 4 °C (b); 20 °C (c); 37 °C (d); and 50 °C (e) and assayed on S. maydis and S. macrospora in PDA.


| Strain bacteria* | Percent of inhibition (%)
| |||||
|---|---|---|---|---|---|---|
| Logarithmic phase | Early stationary phase | Late stationary phase | ||||
| S. maydis | S. macrospora | S. maydis | S. macrospora | S. maydis | S. macrospora | |
| Pseudomonas spp. 11 | 73.0 ± 0.04 | 71.1 ± 0.06 | 73.8 ± 0.06 | 81.0 ± 0.06 | 76.1 ± 0.06 | 81.2 ± 0.08 |
| B. subtilis 13 | 17.8 ± 0.04 | 35.0 ± 0.08 | 76.6 ± 0.04 | 77.4 ± 0.07 | 79.8 ± 0.06 | 79.8 ± 0.05 |
| P. fluorescens 16 | 18.0 ± 0.06 | 19.0 ± 0.04 | 55.2 ± 0.06 | 5.1 ± 0.06 | 24.2 ± 0.04 | 4.0 ± 0.04 |
| P. agglomerans 19 | 0.0 ± 0.00 | 0.0 ± 0.00 | 1.0 ± 0.04 | 7.2 ± 0.05 | 1.0 ± 0.03 | 16.7 ± 0.04 |
| Pseudomonas spp. 21 | 0.0 ± 0.00 | 0.0 ± 0.00 | 1.0 ± 0.02 | 10.4 ± 0.04 | 1.0 ± 0.03 | 3.8 ± 0.06 |
| B. subtilis 35 | 22.8 ± 0.05 | 59.6 ± 0.04 | 73.4 ± 0.04 | 73.3 ± 0.03 | 76.6 ± 0.04 | 81.9 ± 0.03 |
| B. subtilis 55 | 10.4 ± 0.04 | 10.3 ± 0.05 | 88.3 ± 0.01 | 76.9 ± 0.03 | 79.3 ± 0.04 | 74.3 ± 0.04 |
| B. subtilis 135 | 9.6 ± 0.04 | 16.6 ± 0.05 | 88.4 ± 0.05 | 70.8 ± 0.04 | 96.5 ± 0.02 | 84.3 ± 0.04 |
| Pseudomonas spp. 156 | 2.0 ± 0.03 | 0.0 ± 0.00 | 5.0 ± 0.06 | 2.4 ± 0.07 | 5.0 ± 0.06 | 0.8 ± 0.01 |
| B. subtilis 160 | 2.2 ± 0.06 | 34.3 ± 0.04 | 34.4 ± 0.03 | 46.1 ± 0.06 | 89.0 ± 0.05 | 80.0 ± 0.06 |
© 2011 by the authors; licensee MDPI, Basel, Switzerland. This article is an open-access article distributed under the terms and conditions of the Creative Commons Attribution license (http://creativecommons.org/licenses/by/3.0/).
Share and Cite
Petatán-Sagahón, I.; Anducho-Reyes, M.A.; Silva-Rojas, H.V.; Arana-Cuenca, A.; Tellez-Jurado, A.; Cárdenas-Álvarez, I.O.; Mercado-Flores, Y. Isolation of Bacteria with Antifungal Activity against the Phytopathogenic Fungi Stenocarpella maydis and Stenocarpella macrospora. Int. J. Mol. Sci. 2011, 12, 5522-5537. https://doi.org/10.3390/ijms12095522
Petatán-Sagahón I, Anducho-Reyes MA, Silva-Rojas HV, Arana-Cuenca A, Tellez-Jurado A, Cárdenas-Álvarez IO, Mercado-Flores Y. Isolation of Bacteria with Antifungal Activity against the Phytopathogenic Fungi Stenocarpella maydis and Stenocarpella macrospora. International Journal of Molecular Sciences. 2011; 12(9):5522-5537. https://doi.org/10.3390/ijms12095522
Chicago/Turabian StylePetatán-Sagahón, Iván, Miguel Angel Anducho-Reyes, Hilda Victoria Silva-Rojas, Ainhoa Arana-Cuenca, Alejandro Tellez-Jurado, Isabel Oyuki Cárdenas-Álvarez, and Yuridia Mercado-Flores. 2011. "Isolation of Bacteria with Antifungal Activity against the Phytopathogenic Fungi Stenocarpella maydis and Stenocarpella macrospora" International Journal of Molecular Sciences 12, no. 9: 5522-5537. https://doi.org/10.3390/ijms12095522
APA StylePetatán-Sagahón, I., Anducho-Reyes, M. A., Silva-Rojas, H. V., Arana-Cuenca, A., Tellez-Jurado, A., Cárdenas-Álvarez, I. O., & Mercado-Flores, Y. (2011). Isolation of Bacteria with Antifungal Activity against the Phytopathogenic Fungi Stenocarpella maydis and Stenocarpella macrospora. International Journal of Molecular Sciences, 12(9), 5522-5537. https://doi.org/10.3390/ijms12095522

